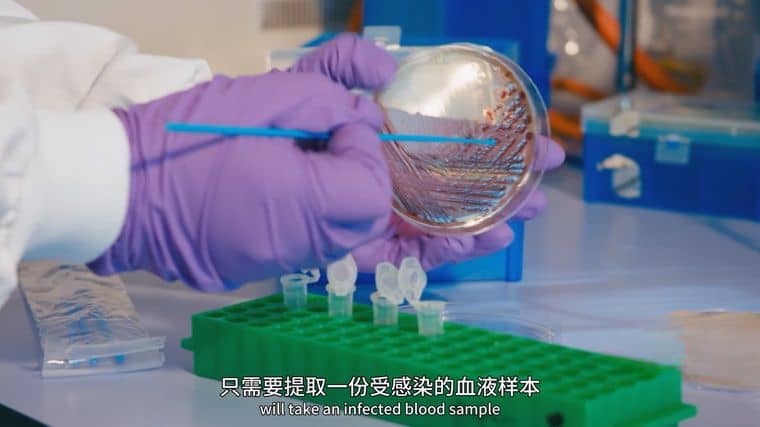

《抗生素的真相》(The Truth About Antibiotics 2019)由Angela Rippon主持,深入探讨抗生素这一“生命救星”的双面性——既拯救了亿万人生命,也因滥用陷入耐药性危机,同时展现科学家寻找替代方案的不懈努力。

抗生素的黄金时代与危机起源
纪录片追溯抗生素的历史转折点:1928年弗莱明发现青霉素,1943年首次用于临床治疗败血症,使二战伤兵死亡率下降80%;20世纪50年代四环素、头孢菌素等陆续问世,肺结核、肺炎等感染性疾病从“绝症”变为可治愈。但“滥用的种子”也随之埋下:农业领域将抗生素作为促生长剂添加到饲料中(全球每年50%抗生素用于畜牧业),医疗领域存在“感冒发烧就用抗生素”的过度处方,甚至患者自行停药导致细菌未被彻底杀灭。这些行为导致耐药菌株加速进化——1961年英国发现首例耐甲氧西林金黄色葡萄球菌(MRSA),2009年印度出现“超级细菌”NDM-1,可抵抗几乎所有抗生素,纪录片通过显微镜镜头直观展示:普通细菌在抗生素作用下迅速死亡,而耐药菌则能形成生物膜“护盾”,甚至主动泵出药物分子。
耐药性的全球连锁反应
影片通过真实案例揭示危机严重性:一名英国女孩因手指划伤感染耐药性大肠杆菌,常规抗生素全部失效,最终依赖实验性噬菌体疗法才保住性命;美国某医院爆发CRE(耐碳青霉烯类肠杆菌科细菌)感染,18名患者中7人死亡,源头追溯至一名曾在印度接受手术的患者。世界卫生组织数据显示,全球每年因耐药菌感染死亡70万人,若不采取措施,2050年这一数字可能达到1000万。更令人担忧的是“交叉耐药”现象:动物体内的耐药基因可通过肉类、水源进入人体,例如养鸡场使用的氟喹诺酮类抗生素,导致人类尿路感染对同类药物的耐药率从1990年的5%升至2019年的30%。纪录片采访的农民坦言:“不用抗生素,鸡群存活率会从95%降到60%,但没人告诉我们代价是人类未来无药可用。”

替代方案的艰难探索
科学家正从多方向突破耐药困局:噬菌体疗法(利用病毒精准攻击特定细菌)在格鲁吉亚已用于临床,成功治愈多例“超级细菌”感染;人工智能筛选新抗生素——MIT团队用AI分析2亿种化合物,发现新型抗生素halicin,可杀灭MRSA且不易产生耐药性;甚至“古老智慧”也被重新审视:从土壤中分离出的放线菌(最初发现抗生素的来源),在亚马逊雨林新物种中发现了20多种潜在抗菌物质。但挑战依然巨大:噬菌体疗法需“一对一”定制,难以规模化生产;新型抗生素研发周期长达10年,成本超10亿美元,而细菌耐药速度远超新药上市速度。纪录片结尾,一位微生物学家在实验室培养皿前说:“我们与细菌的战争,本质是进化速度的竞赛——人类不能再傲慢地认为自己是赢家。”

影片以“历史-现状-未来”为脉络,通过动画演示抗生素作用机制(如抑制细胞壁合成、干扰蛋白质生产)、耐药菌进化过程,搭配医院ICU、养鸡场、实验室的真实场景,展现危机的紧迫性与复杂性。Angela Rippon的解说既包含严谨数据(如“全球每年抗生素处方中30%不必要”),也不乏人文关怀——当采访耐药菌患者时,她轻声问道:“当医生说‘没药了’,你是什么感受?”这种平衡让科学议题既有警示意义,又触动人心。
